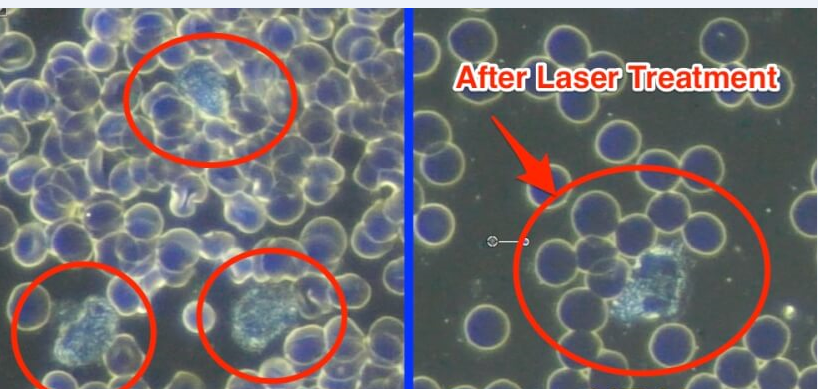

What`s the treatment range of the laser intranasal light therapy device?
Rhinitis, like allergic rhinitis, acute rhinitis, chronic rhinitis, nasal sinusitis and nasal polyps.
What`s the Function and Performance of the laser intranasal light therapy device?
1 reducing the blood viscosity.
2 accelerating the blood circulation within the nasal tissues.
3 enhancing local blood oxygen saturation,
4 accelerating the absorption and metabolism of nasal tissue to inflammatory substances,
5 eliminating and reducing the nasal obstruction caused by nasal swelling.
6 promoting the secretion of lysozyme and phagocytes within the nasal mucosa,
7 improving the immunization and sterilization function of the nasal mucosa.
8 improving the nasal antivirus/germs ability and the antianaphylaxis ability.
9 accelerating the convergence of the damaged nasal mucosa,
10 repairing damaged blood capillary and prevent the regular nosebleed.
11 accelerating and improving the swinging of cilia on the nasal mucosa.
12 enhancing the nasal function and strengthening the detoxification ability of the nasal mucosa.

What`s the Features of the laser intranasal light therapy device?
1. No medical or chemical components, without pain, damage or stimulation during treatment.
2. Short treatment time, 15-20 mines each time.
3. Small in size, easy to carry. It is very compact and portable.
4. LCD display screen and with easy operation buttons.
5. Two output modes: Pulse and Continues.
6. Pluggable laser wire, more convenience in use and easier maintenance.
Cold Laser clinical study for rhinitis treatment

How does laser treat rhinitis?
The Rhinitis Therapeutic Instrument mainly adopts the special soft laser light (650nm) which can get through the nasal mucosa of the human body. The soft laser light is featured mild working rate and could be fully and safety absorbed by the nasal tissue of the human body. This kind of laser light has a special repair function to the nasal mucosa of the rhinitis patients. The repaired nasal mucosa could secrete antibacterial material including lysozyme as normal mucosa and restart the normal cleaning function of the swinging cilia on the nasal mucosa.


In summery, the treatment method of Rhinitis Therapeutic Instrument is based on the fundamental principle of repairing and improving the body's natural immune system. Quickly remediate the wounded surface through irradiating the surface of the damaged mucous membrane; improve the partial blood circulation around the nasal cavities and the immunological competence of the nasal mucosa membranes through irradiating the the nasal mucosa, thereby playing a good role in treating allergic rhinitis, chronic rhinitis, nasal sinusitus and the like.
How does Laser Therapy Watch Treat Hypertension?
The laser wrist watch is adopted eleven 650nm low-level laser, when cold laser watch irradiates defined acupuncture points on the wrist (radial artery, Antigenic point and nasal cavity appoint), the energy light can be absorbed by cells, to stimulates protein synthesis, help to clean blood vessel waste, improve oxygen-carrying capacity of red blood cells, accelerate blood circulation & human metabolism, reduce high blood viscosity, blood sugar, blood fat, blood pressure, repair damaged nasal mucous and cure rhinitis at the same time.
What's more, the laser watch can also irradiate the inner area of the nose using the adapter included. The inner area of the nose comprises a multitude of capillaries. The nerves in the nose are stimulated, the blood circulation in the skull is improved and in total the local articulation is thus improved. Furthermore, as a result of the stimulation, more oxygen should be made available in the brain.
By increasing the activity of fibroblasts cozing laser light optimizes wound healing and improves the oxygen utilization in the tissue. Due to its anti-inflammatory effects, the Cozing laser pad also can be used very successfully in dermatology.
Product details


Rhinitis Therapy Device Laser Nose Health Laser Massage Machine
- Product Code: COZING-BQ01
- Availability: In Stock
-
$109.00
- Ex Tax: $109.00
Tags: Laser physiotherapy, Acupuncture laser, Rhinitis Sinusitis, Low Level Laser, Physical therapy rehabilitation laser, Laser treatment of rhinitis






